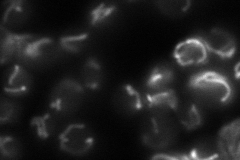
YBL064C
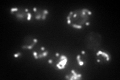
YBL064C

View description
Mitochondrial peroxiredoxin (1-Cys Prx) with thioredoxin peroxidase activity, has a role in reduction of hydroperoxides; reactivation requires Trr2p and glutathione; induced during respiratory growth and oxidative stress; phosphorylated
Localization:
Intensity:
Fold change:
Significance:
-
C’ GFP library in SD

mitochondria64.52 -
N' NOP1pr-GFP in SD

mitochondria272.061 -
N' TEF2pr-mCherry in SD

mitochondria328.18 -
N' NATIVEpr-GFP in SD
mitochondria76.1807 -
N' TEF2pr-VC and Cyto-VN in SD

#N/A0 -
C’ GFP library in SD+DTT

mitochondria120.681.87Yes -
C’ GFP library in SD+H2O2

mitochondria75.451.16No -
C’ GFP library in Starvation Media
mitochondria237.883.68Yes -
C’ GFP library on the background of Pup2-DaMP

mitochondria -
C’ GFP library on the background of CCT mutant

mitochondria91.72631.42147Yes
